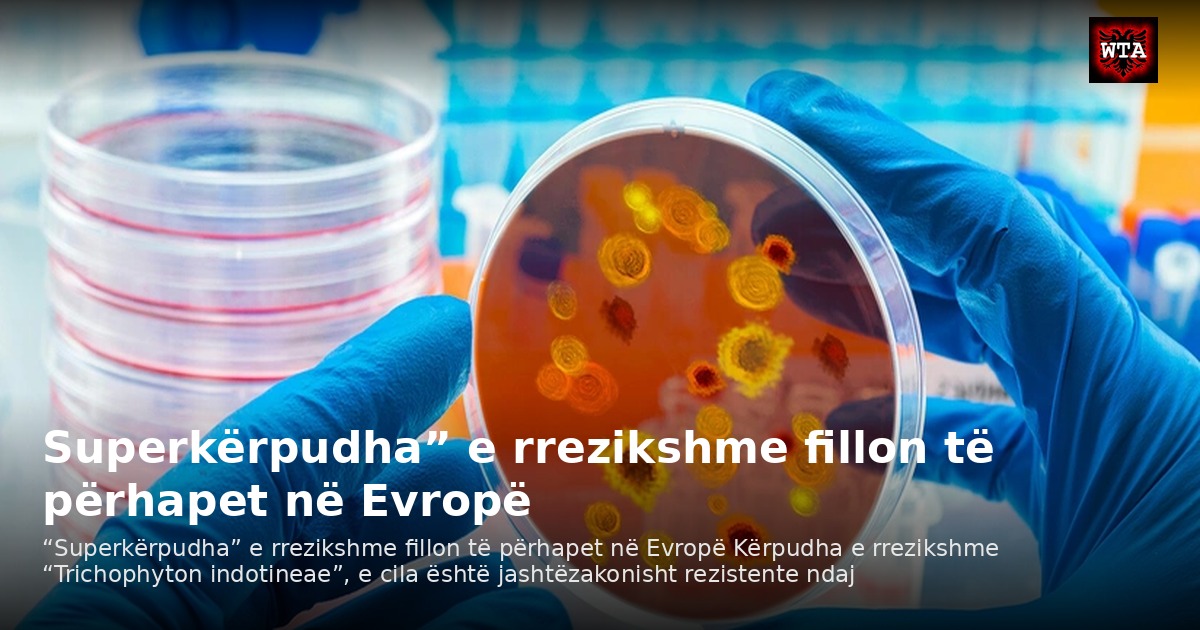
Superkërpudha” e rrezikshme fillon të përhapet në Evropë

Pikat kryesore
- Sipas David Denning, një ekspert i sëmundjeve infektive në Universitetin e Mançesterit, ky lloj kërpudhe shkakton një skuqje të kuqe dhe kruajtëse që zakonisht shfaqet në ijë, kofshë dhe vithe.
- Artikulli vëren se në tre vitet e fundit, rastet e infeksionit me Trichophyton indotineae në Mbretërinë e Bashkuar janë rritur me pothuajse 500%.
- Kërpudha përhapet nëpërmjet kontaktit të drejtpërdrejtë me një person të infektuar, nëpërmjet sipërfaqeve të kontaminuara ose seksualisht.
“Superkërpudha” e rrezikshme fillon të përhapet në Evropë Kërpudha e rrezikshme “Trichophyton indotineae”, e cila është jashtëzakonisht rezistente ndaj trajtimit dhe tashmë është quajtur “super kërpudhë”, po përhapet në vendet evropiane. Sipas David Denning, një ekspert i sëmundjeve infektive në Universitetin e Mançesterit, ky lloj kërpudhe shkakton një skuqje të kuqe dhe kruajtëse që zakonisht shfaqet në ijë, kofshë dhe vithe. Artikulli vëren se në tre vitet e fundit, rastet e infeksionit me Trichophyton indotineae në Mbretërinë e Bashkuar janë rritur me pothuajse 500%. Kërpudha përhapet nëpërmjet kontaktit të drejtpërdrejtë me një person të infektuar, nëpërmjet sipërfaqeve të kontaminuara ose seksualisht. Denning shprehu besim se përhapja e kërpudhës do të bëhet një problem i madh në të gjithë botën. loading…